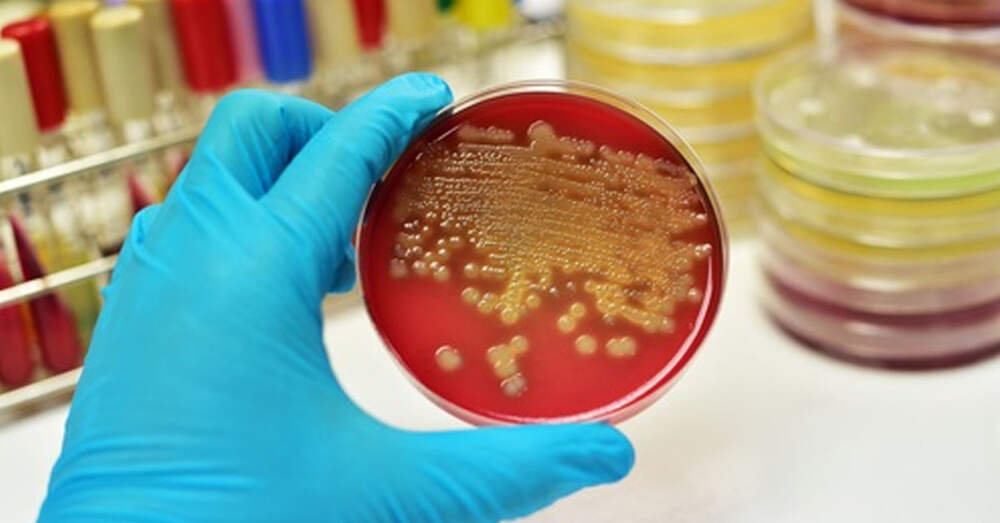

Плоский живот: 6 простых упражнений, которые вы можете выполнять сидя
Все больше и больше людей работают таким образом, что они практически вынуждены оставаться сидящими большую часть дня, особенно те, кто работает в офисе. Длительное сидение имеет разрушительные последствия как для здоровья, так и для увеличения размера талии, накопления жира и воспаления! Но есть
...Далее

Свежие комментарии